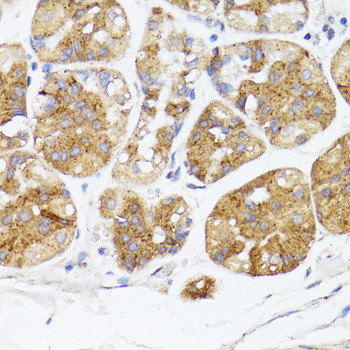
BMPR2 Antibody in Immunohistochemistry (Paraffin) (IHC (P))

Search
Invitrogen
BMPR2 Polyclonal Antibody
{{$productOrderCtrl.translations['antibody.pdp.commerceCard.promotion.promotions']}}
{{$productOrderCtrl.translations['antibody.pdp.commerceCard.promotion.viewpromo']}}
{{$productOrderCtrl.translations['antibody.pdp.commerceCard.promotion.promocode']}}: {{promo.promoCode}} {{promo.promoTitle}} {{promo.promoDescription}}. {{$productOrderCtrl.translations['antibody.pdp.commerceCard.promotion.learnmore']}}
图: 1 / 4
BMPR2 Antibody (PA5-95839) in IHC (P)




产品信息
PA5-95839
宿主/亚型
分类
类型
抗原
偶联物
形式
浓度
规格
保存条件
运输条件
RRID
产品详细信息
Positive Samples: mouse lung, rat kidney
靶标信息
BMPR2 is a member of the bone morphogenetic protein (BMP) receptor family of transmembrane serine/threonine kinases. The ligands of this receptor are BMPs that are involved in endochondral bone formation and embryogenesis. The loss of interaction and lack of phosphorylation of TCTEL1 by BMPR2 may contribute to the pathogenesis of primary pulmonary hypertension (PPH) and BMPR2 also plays an essential role in human T-cell differentiation. BMPs are involved in endochondral bone formation and embryogenesis. These proteins transduce their signals through the formation of heteromeric complexes of two different types of serine (threonine) kinase receptors: type I receptors of about 50-55 kDa and type II receptors of about 70-80 kDa. Type II receptors bind ligands in the absence of type I receptors, but they require their respective type I receptors for signaling, whereas type I receptors require their respective type II receptors for ligand binding. Mutations in BMPR2 have been associated with primary pulmonary hypertension, both familial and fenfluramine-associated, and with pulmonary venoocclusive disease.
仅用于科研。不用于诊断过程。未经明确授权不得转售。